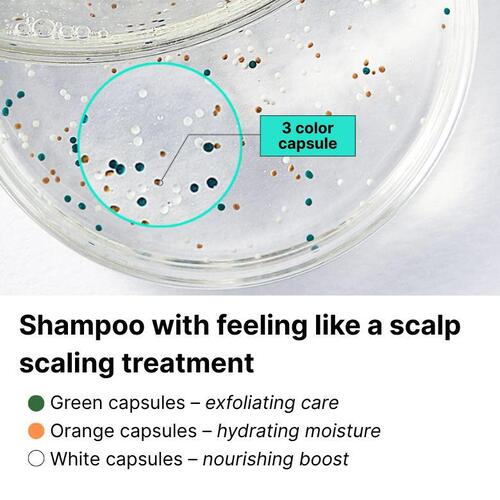
LABO-H Haarausfall-Linderung Kopfhautkühlung & Talgkontroll-Shampoo 400ml

Dein Browser unterstützt die Seite nicht. Bitte aktualisiere deinen Browser oder lade einen anderen herunter
LABO-H Haarausfall-Linderung Kopfhautkühlung & Talgkontroll-Shampoo 400ml
Aktueller Preis
Preis 62,47 €inklusive MwSt.

FarbeWie abgebildet
Lieferung innerhalb von 🇩🇪 Deutschland
8–11 Werktage · 4 € pro Bestellung
Sichere Zahlungen und Datenschutz







Sicherheit & Konformität

Hersteller
Eigenschaften
Volumen
400 ml
Beschreibung
Beauty Box Korea
4,8/6.000+
Ähnliche Produkte